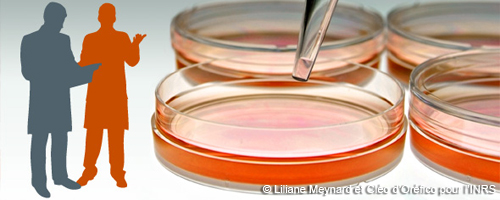
Activités de recherche

Activités de recherche
La recherche à l’INRS vise à améliorer les connaissances en santé et sécurité du travail. Pour cela, elle s’attache à la production de nouveaux savoirs ainsi qu'à la conception de solutions de prévention efficaces.
La recherche à l’INRS vise à améliorer les connaissances en santé et sécurité du travail. Pour cela, elle s’attache à la production de nouveaux savoirs ainsi qu'à la conception de solutions de prévention efficaces.
L’activité de recherche contribue ainsi aux actions de formation, d’information et d’assistance de l’INRS.
Une commission scientifique indépendante est chargée de l'évaluation scientifique des travaux de recherche conduits à l'INRS. Elle s’assure de la pertinence de la méthode utilisée et de la validité des résultats obtenus.
Les résultats des travaux de recherche sont publiés dans des revues scientifiques et professionnelles accessibles à tous.




